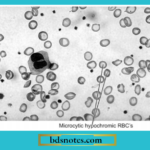
Iron Deficiency Anemia Blood Film

Classification of Anemia "What is the classification of anemia and why is it important?" Pathophysiologic Anemia due to increased blood loss Acute post-hemorrhagic anemia Chronic blood loss. Anemia due to impaired red cell function: Cytoplasmic maturation defect: Deficient heme synthesis, i.e., iron deficiency anemia Defective globin … [Read more...] about Classification of Anemia
Pathology
What Is a Giant Cell Tumor of Bone and How Is It Diagnosed?
What Is a Giant Cell Tumor of Bone and How Is It Diagnosed? Write a short note on a giant cell tumor of bone. Or Write a short note on a giant cell tumor of bone. Or Write a short note on giant cell tumors. Answer: "Understanding the role of giant cell tumors in bone health" Giant cell tumor of bone A giant cell tumor of bone is also known as … [Read more...] about What Is a Giant Cell Tumor of Bone and How Is It Diagnosed?
Hypertension Question And Answers
Hypertension Question And Answers Question 1. Write a note on the pathophysiology of hypertension. Answer: Hypertension is a chronic elevation of blood pressure that, in the long term, causes end-organ damage and results in increased morbidity and mortality. The specific trigger is not known. Probable factors that play significant roles are: "Understanding the role of … [Read more...] about Hypertension Question And Answers
Hemodynamic Changes Question And Answers
Hemodynamic Changes Question And Answers Write a short note on the mechanism of edema. Or Write in short on the pathophysiology of edema. hemodynamic changes questions and answers Answer: The word edema means swelling. "Understanding the role of hemodynamic changes in cardiovascular health" "Importance of studying hemodynamic changes for better healthcare … [Read more...] about Hemodynamic Changes Question And Answers
Immunopathology Including Amyloidosis Question And Answers
Immunopathology Including Amyloidosis Question And Answers Question 1. Write a short note on laboratory diagnosis of AIDS. Answer: Laboratory Diagnosis of AIDS "Understanding the role of immunopathology in disease mechanisms" 1. Tests for Establishing HIV Infection Antibody tests: ELISA Western blot Direct detection of HIV p24 antigen … [Read more...] about Immunopathology Including Amyloidosis Question And Answers